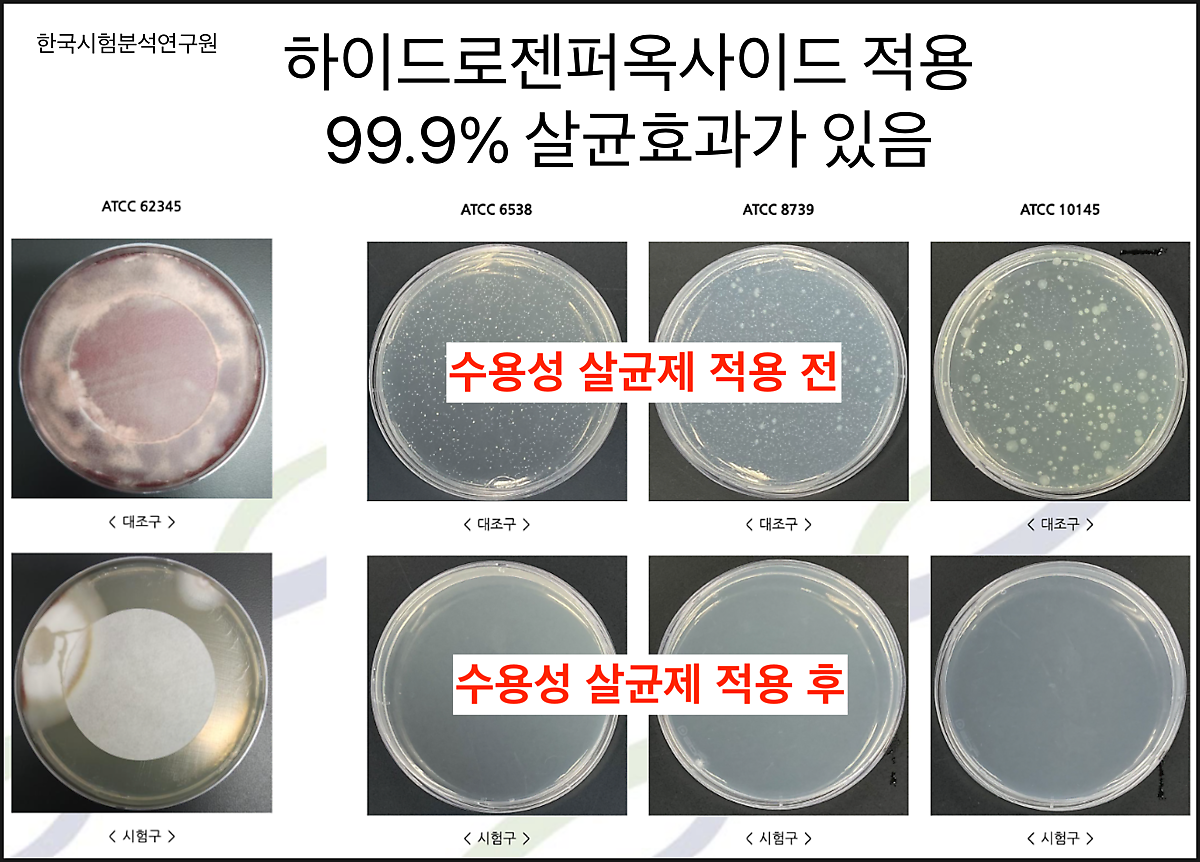

발톱무좀, 돈 아끼고 시간 아끼는 해결법
먼저,
당신의 발톱이
아래와 같은 수준이라면
당장 병원에 가세요.
무좀은 곰팡이에 의한 저항력이
떨어지는 것에서부터 생기는데
저정도면 면역이상, 장누수증
혈액문제까지 전체적으로
상황이 나빠 보입니다.
저정도가 아니라면
딱 3분만 투자해서
제가 무좀을 해결한 스토리와
경험을 받아가세요.
이 글을 통해 얻을 수 있는 것을
제시해 드립니다.
1. 병원없이 집에서 완치한다.
2. 시간을 많이 아낀다.
3. 돈을 정말 많이 아낀다.
4. 간독성, 장누수를 피한다.


저는 20년동안
보이지 않는 영양을 통해
보이는 건강을 알리는
영양기능학자로 살아왔습니다.
비타민 & 영양제 케어부터
중금속 해독, 장누수 케어까지
어디 하나 문제될 것 없이
건강하게 살아왔어요.

챙겨먹는 영양제들 - 우측부터 오메가3, 비타민B, 코큐텐, 비타민D, 아연, 유산균. 인돌3카비놀, msm, 아미노산복합체, 포스파티딜세린, 가바, 테아닌, 마카, 아르기닌 등
그러던 한 날 발가락이
간지러워 미칠것 같은거에요.
건강에 자신이 있었던지라
별 대수롭지 않게 생각하고
그냥 넘겼습니다.
그런데 시간이 지날수록
발가락이 더 가렵고
꼬리한 냄새가 났어요.

생각없이 방치하고 살다보니
이게 발톱무좀이라는 걸
뒤늦게 알게됐습니다 ^^;;;
해결하러 병원에 갔더니만
이트라코나졸, 플루코나졸 같은
항생제를 주는거에요.
이런 항생제는
백 . 해 . 무 . 익 입니다.
항생제는 유익균과 유해균
구별을 못해요.

무좀약은 오래먹어야 하는데,
그렇게 장내 유익균들이 다 죽고
면역체계가 붕괴되면서
간독성, 장누수, 자가면역질환에
시달리게 되는거에요.
이런 원리를 알면
쳐다보기도 싫으실겁니다

그래서 제가 스스로
해결하려고 이것저것
자료를 좀 찾아봤습니다.

무좀균은 사실 굉장히 사멸하기
쉬운 균 이더라고요.
그런데 발톱사이에 있는
무좀균은 특별합니다.
발톱을 방패삼아서 생존하도록
진화된거거든요. 똑똑한거죠.


그 말인 즉슨
하이드로젠퍼옥사이드나
포비돈아이오딘
소디움하이포콜로레트 같은
살균성분을 발톱안으로
투과 시킬수만 있으면
무좀은 해결된다는 거죠.
이건 이미 과학적으로 전부
증명된 사실이에요.
생각보다 발톱을 투과시키는건
매우 간단합니다.
살균제들은 수용성 물질들이라서
살갗같은 피부에는 흡수가 쉬운데,
발톱같이 지질로 구성된
두꺼운 각질은 투과가 어렵죠.
그래서 화학적각질제거제로
최대한 말랑말랑하게 해야합니다.

그러면 수용성 살균제는
쉽게 흡수가 됩니다.
이 과정에서 제균이 진행이 되는데
거품현상이 발생됩니다.



하지만 이렇게 해도
흡수되는 살균제량은
소량이기 때문에
충분하게 효과를 보려면
1달은 꾸준하게
관리해야 합니다.
저는 시중에 있는 손발톱 전용
살균제로 관리했습니다.
<관리 2달 차>

<관리 3달 차>
